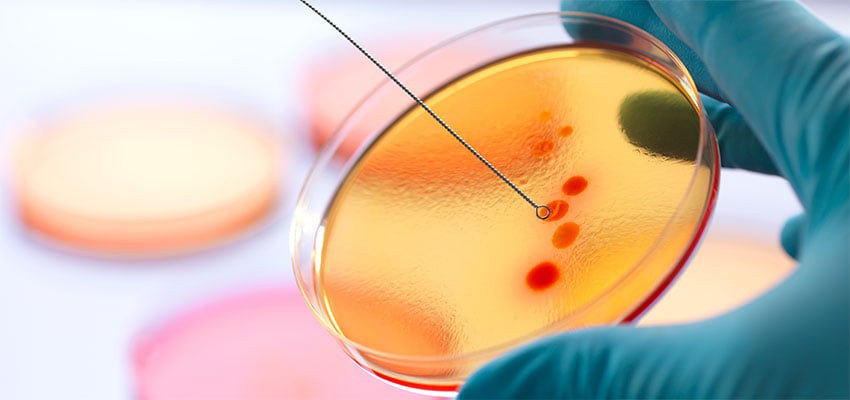

Health
Make Science Make a Difference
Predict. Protect. Perform.
Our team of expert problem-solvers are as
passionate as you are about finding solutions to the world’s most
pressing health challenges. Combining decades of experience with
the tools and resources to push the limits of what’s possible, we turn
research, theories and ideas into practical solutions that impact lives.
How We Can Help

Medical Devices
Research and innovation helping you push boundaries, create new markets, and develop best-in-class technology to improve human health and well-being.
Explore Medical Devices
Featured Solutions
Life Sciences Research
Featured Solutions

Public Health
Battelle leverages global, public, and environmental health research to inform program and policy decisions on a broad range of public health issues - from infectious disease prevention to health preparedness.
Featured Solutions

Chemical and Biological Countermeasures
Battelle's proactive approach pairs research with long-standing expertise to deliver solutions to foresee, assess, and respond to chemical and biological threats.
Featured Solutions

Human Health and Performance
Featured Solutions
Accelerating Human Health and Performance

Advancing Health Where It Matters Most
Battelle applies science, technology, and evidence‑based insights to protect against public health threats, strengthen quality patient care, and improve access to quality healthcare for communities worldwide. From biosecurity and pandemic preparedness to medical countermeasures, diagnostics, and military health solutions, our work supports resilient health systems and improves outcomes for patients, service members, and those on the front lines of care.
Related Expertise
Case Studies
Join the Battelle Team
Technology Commercialization and Licensing
With over 90 years of research and development experience, Battelle supports all areas of industry with “out of the box” thinking that is focused on medical and diagnostic devices, neurotechnology, health research and data analytics,
pharmaceutical sciences, public health and more.
